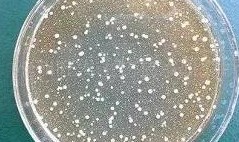
色翁荡息又大又硬又粗又爽

色翁荡息又大又硬又粗又爽-午夜亚洲福利av-在线观看黄网视频免费播放-日本三级吃奶头添泬玉蒲团-欧美精品综合一区二区在线观看
地址:山东省.泰安市.泰前
电 话:0538-8505866
传 真:0538-8505966
财富热线:18660886576
枯草芽孢杆菌生长快、营养简单,能产生耐热、抗逆的芽孢,可以制成各种剂型;与化学农药混用而不失活,而且批量生产工艺简单,成本也较低,施用方便,储存期长。实乃种植生产,良药!
1,营养和空间位点的竞争
枯草芽孢杆菌的竞争作用主要包括营养竞争和空间位点竞争。可以在植物根际、 体表或体内及土壤中快速、大量繁衍和定殖,有效地排斥、阻止和干扰植物病原微生物在植物上的定殖与侵染,从而达到抑菌和防病的效果。
2,产生抑菌物质
枯草芽孢杆菌在生长过程中能产生多种具有抑菌、溶菌作用的物质,如枯草菌素、有机酸、抗菌蛋白等等,这些物质可以控制病原菌的生长和繁殖,甚至破坏细菌结构,杀死病原菌。因此,枯草芽孢杆菌对于重茬病、根腐病、灰霉病等疾病防治效果很好。
3,增强免疫促进生长
枯草芽孢杆菌可以分泌活性物质,激活植物防御系统,增强作物的免疫力与抗病性,减轻或消除病原菌对植株的危害。
4,诱导植物产生抗性
枯草芽孢杆菌不但能直接控制植物病原菌,而且能通过诱发植物自身的抗病潜能从而增强植物的抗病性。如水稻纹枯病生防菌枯草芽孢杆菌,能诱导水稻叶鞘细胞抗病相关的酶(POD、PPO和SOD)活性增强,达到抗病效果。
5,改善土壤结构
枯草芽孢杆菌在土壤中形成益生菌环境,促进团粒结构形成,提高土壤保肥保水能力,增加土壤疏松度,促进根系生长。具体表现在,加速养料矿质化,将养分由无效态和缓效态变为有效态。同时,加速养料腐殖化,分泌植酸酶,降解土壤中大部分的植酸盐;产生生长素,刺激作物生长,提高种子的成活率和出苗率。
1. 抗生作用
抗生作用是指拈抗微生物通过产生代谢产物在低浓度下就能够对病原微生物的生长和 代谢产生控制作用,从而来影响病原微生物的生存和活动。近半个世纪以来,人们从枯草芽孢杆菌不同菌株的代谢产物中分离纯化了多种有效的抗菌物质。
2 溶菌作用
枯草芽孢杆菌的溶菌作用主要表现在是通过吸附在病原菌的菌丝上,并随着菌丝生长 而生长,而后产生溶菌物质造成原生质泄露使得菌丝体断裂;或者是产生抗菌物质通过溶解病原菌孢子的细胞壁或细胞膜,致使细胞壁穿孔、畸形等现象从而控制孢子萌发。
3 诱导植物产生抗性及促进植物生长
诱导植物产生抗性作用是指枯草芽孢杆菌不但能够控制植物病原菌,而且还能够诱 发植物自身抗病机制从而增强植物的抗病性能的作用。什么是PGPR国际上把土壤中能促进植物生长的根际自生细菌通称为植物促生根圈细菌 (Plant growth promoting rhizobaceria),简称为PGPR。
4 保护环境。
枯草芽孢杆菌大量应用于生物肥料。当作用于作物或土壤时,能够在作物根际或体内定殖,并起到特定肥料效应。目前,微生物肥料在培肥地力,提高化肥利用率,控制农作物对硝态氮、重金属、农药的吸收,净化和修复土壤,降低农作物病害发生,促进农作物秸秆和城市垃圾的腐熟利用。提高农作物产品品质和食品等方面表现出了不可替代的作用。
5 枯草芽孢杆菌对土壤中的菲与苯并芘的吸附及生物降解功能
土壤与其相连的水环境称为土壤-水环境系统,其中存在着大量的土壤固有微生物,并在表面存在生物膜,因为生物膜形成了隔离层,有机污染物在接触到支撑生物膜的固体基底之前,首先到达并且穿过这个隔离层,这样就强烈地改变矿物颗粒或基底的吸附行为,对吸附作用有重要的影响,近年的研究表明,由于受污染影响,导致土壤中含有多环芳烃(PAHs),沉积物中PAHs主要为原油污染以及工业或民用煤不完全燃烧所致,枯草芽孢杆菌对菲与苯并芘的吸附及生物降解研究,研究表明以枯草芽孢杆菌为接种微生物,对菲与苯并芘都可进行吸附或生物降解,48h液相PAHs浓度达到平衡时,微生物对菲消除了98%,对苯并芘消除85%;接种的样品48h吸附等温线均呈线形,能较好地符合线性方程;在接种微生物情况下,沉积物与土壤对菲和苯并芘吸附特征均发生较大变化,对菲的吸附量变大约35倍,而对苯并芘的吸附量却降低了2/3左右;未接种微生物的土壤和沉积物对菲解吸率为20%,接种的样品组为2.9%,而对苯并芘的解吸结果与菲相反,未接种的对照组为4%,接种的样品组为l3%。
6 枯草芽孢杆菌对土壤微生物的呼吸强度的影响
土壤呼吸强度作为土壤生物活性指标之一,能够在一定程度上反应土壤营养物的转化和供应能力,其呼吸速率变化及变化方向也反应了生态系统对胁迫的敏感程度和响应模式,是环境评价的一项重要指标,当土壤受到外来污染物污染时,微生物为了维持生存可能需要更多的能量,而使土壤微生物的代谢活性发生不同程度的响应。研究表明各质量分数处理的枯草芽孢杆菌均表现为对土壤呼吸作用的刺激效应,并且土壤中枯草芽孢杆菌质量分数越大,对土壤呼吸强度的刺激作用越大,即刺激强度和施药质量分数呈正相关。
7 枯草芽孢杆菌对土壤脲酶活性的影响
应用土壤酶作为监测指标,评价农药的生态毒理效应已成为环境科学领域的研究热点之一。而脲酶属于土壤中研究得比较深入的一种水解酶类,是惟一对尿素在土壤中转化及尿素利用率有重大影响的酶。尿素施人土壤后,在脲酶的催化作用下,迅速分解成二氧化碳和氨,所以土壤脲酶活性的降低,不仅可使尿素水解减缓,令其水解产物更多地被土壤吸附而有效减少尿素水解产物氨的挥发损失,也可能相应减少水解产物NH硝化作用潜势。
8 枯草芽孢杆菌对盐碱地的改良
土壤内盐分积累的危害 土壤结构黏滞,通气性差,容重高,土温上升,好气性微生物活动差,养分释放慢,渗透系数低,毛细作用强等,导致表层土壤盐渍化进一步加剧,造成土壤冷、硬、板现象。一般说来,当土壤表层或亚表层中的水溶性盐类累积累超过0.1%,或土壤碱化层的碱化度超过5%,就属于盐渍土。